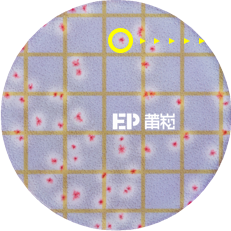
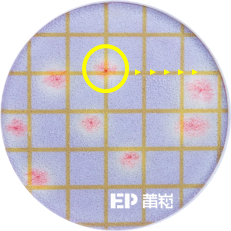

- 更安心:公定分析法(AOAC-OMA)官方方法認證(字號2025.01),為快檢方法中獲最高層級的認證法
- 更清楚:菌相更清晰、高對比菌落易計數,乳白色暈環(卵磷脂酶)提供更確切的驗證
- 更便捷:24 ± 2小時內提供計 仙人掌桿菌的計數結果,無需預先增殖病原菌
- 更全面:可檢測完整的仙人掌桿菌菌群(Bacillus cereus sensu lato group),涵蓋B. cytotoxicus(為MYP瓊脂培養基可檢出的食源性病原菌)
- 接軌規範:產孢性細菌包括產氣莢膜桿菌及仙人掌桿菌之最大容許量每公克應在100個以下 ▶ 詳見食藥署”污染食品或食品添加物食品中毒原因菌或食品中毒原因微生物名稱表“
- 提供備妥樣品的培養基系統,可省略製備培養基/培養皿等耗時、麻煩的步驟
- 高規認證:
①公定分析法(AOAC-OMA)官方方法(字號2025.01)
②公定分析法(AOAC-RI PTM)認證法(字號042502)
③歐洲MicroVal認證(字號2023LR132) - 相較於傳統培養皿檢測方法,3M/Neogen™ Petrifilm™ 快檢片減少了85%的空間應用、75%的能源使用、79%的水源使用、75%的溫室氣體產生、以及66%的廢棄物產生(以重量和體積估計)
- 國際間各企業信任3M/Neogen™ Petrifilm™ 快檢片的檢測結果,可得到準確、有效、一致的結果
3M/Neogen™ Petrifilm™ 仙人掌桿菌快檢片[6482]
- 培養24±2小時(至多26小時)@35±1℃( 或30±1 ℃)
- 培養後呈現獨特的帶有乳白色/白色暈環 紅紫色菌落的仙人掌桿菌
- 規格、操作條件 & 使用限制:
0
每包片數(片)
0
培養堆疊片數上限(片)
0
最佳計數範圍≤ (CFU)
0
培養面積(cm²)
0
培養溫度±1℃(或30±1℃)
0
培養時數±2小時
☞ 參考菌落:請移動滑鼠至下列圖例


清晰明瞭
(小菌落型)


暈環清晰
(大菌落型)


暈環易辨
(黃底菌落型)

清晰明瞭
(小菌落型)

暈環清晰
(大菌落型)


暈環易辨
(黃底菌落型)
☞ 雜菌菌落:


雜菌紅菌落
無乳白暈環


雜菌藍菌落
無乳白暈環
☞ 雜菌菌落:


雜菌紅菌落
無乳白暈環


雜菌藍菌落
無乳白暈環
解決其他快檢常見的難題 SOLVE DIFFICULTIES IN INTERPRETATIONS
3M™ Petrifilm™ 快檢片的優勢
在現今的環境中,食品安全越來越受重視,品質要求日益嚴格,實驗室面臨著壓力,必須提供快速、可靠和一致準確的測試。3M™ Petrifilm™ 快檢片已證明了具有穩定的性能,擁有200多項認證、評鑑、核准且歷經同業審查。30多年來,世界各地的食品安全專業人員都將信任託付於3M™ Petrifilm™ 快檢片,因為3M™ Petrifilm™ 快檢片以效率化、標準化和簡化微生物質量指示劑測試的過程,提高生產力,並確保優質的產品品質。
產品資源 RESOURCES
手冊 BROCHURES
認證一覽表 REGULATORY MATERIALS
- 公定分析法(AOAC-OMA)官方方法(字號2025.01)(PDF)
- 公定分析法(AOAC-RI PTM)認證法(字號042502)(PDF)
- 歐洲MicroVal認證:字號2023LR132(PDF)、聲明(PDF)
物質安全資料 SAFETY DATA SHEETS (SDS)















